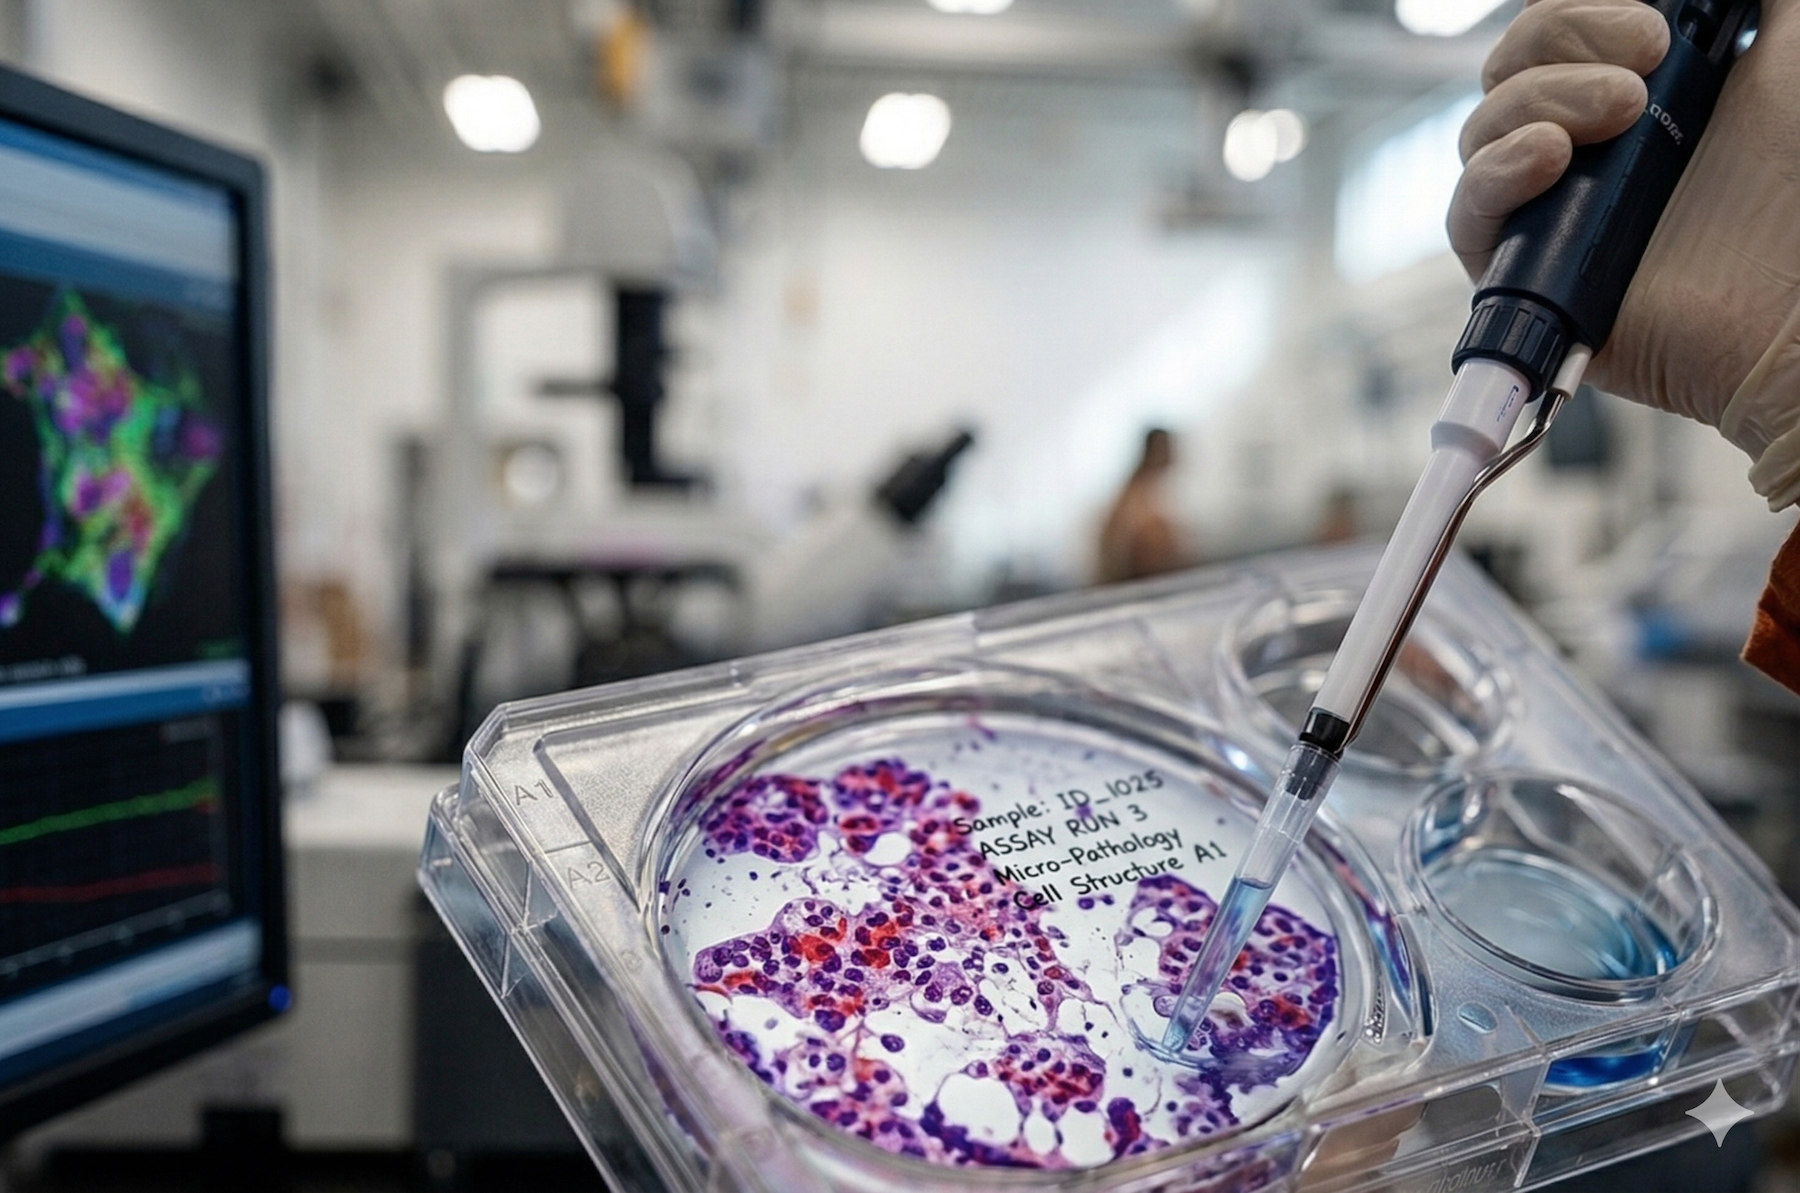

Zaelab builds B2B commerce experiences on the world's best platforms — including Shopify, BigCommerce, and commercetools — that help your customers buy even the most complex products with ease.
Sell more by putting your most complex product knowledge into an AI-powered engine your whole team can use. Zaelab's LogiKit accelerates your ServiceNow CPQ implementation so you can start selling 40% sooner.
When field service, asset management, and customer support run with the same context, your team stops firefighting and starts selling. Every service touchpoint becomes an opportunity to drive retention, upsells, and revenue.

Three continents. Three platforms. One unified digital experience, delivered in nine months. GE's Fortune 100 lighting division consolidated commerce operations across North America, EMEA, and Latin America.
Read the GE Story →
Milwaukee Tool partnered with Zaelab to modernize their B2B sales operations and streamline order processing across North America and LATAM using SAP Commerce Cloud and Portul™.
Read the Milwaukee Story →.png)
Zaelab enhanced BioIVT's ability to manage a complex product portfolio across seven diverse businesses facing numerous automation challenges. We optimized SAP Commerce and Algolia to deliver clarity at scale.
Read the BioIVT Story →
We helped Panduit get AI-driven cross-sells in 1 out of 4 orders, enabling sales reps and distributors to deliver precise product recommendations and turn the buying experience into a revenue engine.
Read the Story →.png)

Our Customer First. Revenue, Now.™ framework unites commerce, rev-ops, and service. All on ServiceNow, with AI at every touchpoint, selling the way your customers want to buy.
Our Approach to a Connected Vision →Self-service discovery and frictionless purchasing.
Accelerate complex quotes with AI. Cut weeks to hours.
Intelligent agreements and automated fulfillment.
Smart dispatch and guided field service.
AI-driven support, repair, and proactive monitoring.
Upsell, amend, renew — and grow.
Automate your CPQ implementation on ServiceNow. No manual rule building required.
View Page →No-code integration between ServiceNow and your existing enterprise systems.
View Page →Free commerce assessment tool — see where your B2B business stands against the competition.
View Page →Zaelab brings something hard to find: deep manufacturing industry understanding paired with modern experience design. They don't need to be taught how our business works — they already understand our customers, our distributors, and the complexity of operating at scale. That allows us to move faster and think more ambitiously about how we serve our customers.
Over 15 years working with manufacturers, medtech, and technology leaders on complex catalogs, customer-specific pricing, ERP integrations, and multi-location account structures. We know what's hard before the first meeting.
From Portul for B2B commerce on Shopify, to Fuse for SAP integration, to LogiKit for CPQ — our tools are built for the complexity B2B businesses face every day. Explore our accelerators.
Most implementations solve one piece of the puzzle. We connect all three so your customers experience a single journey and your teams have full visibility across every touchpoint.
Our managed services team are strategists, not administrators. They work alongside you to see where your business is headed and make sure every new capability builds toward a smarter, more connected operation.





